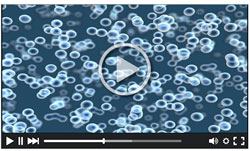
Scrubbing Bubbles

Enjoying Practical Health Today? Make sure you never miss an issue...
Click Here to confirm your subscription. | 
| | | | | | They Don't Teach This at Med School | | | Today's edition of Practical Health Today features a conversation between Senior Health Researcher Matthew Makowski and functional medicine expert Dr. Phil Roberts on the topic of fighting the aging process. The following is an edited excerpt from the discussion.
| | | Matthew Makowski: We've all got a friend or relative who acts years - if not decades - younger than they really are. Shoot, I consider you the kind of guy to fit that bill. So spill the beans, Dr. Phil. What's the big secret?
Dr. Phil Roberts: Well, for starters, I haven't always been healthy as a May morning.
Just a couple of decades into working in the ER, I felt myself slipping. I was forgetting stuff I'd known for years.
Normal snap judgement decisions were more like a slow clap. I was starting to feel like an old ballplayer who outlived his stay in the pros... and was about to be sent back down to the minors.
MM: You were what, in your 50s at the time? To be fair, that is getting up there for a ballplayer.
PR: I was 53. And sure, that might be the case... but 53 sure isn't old for a practicing physician. And it's way too young to be dealing with the scary thought of early onset Alzheimer's disease.
MM: You're absolutely right. So what changed? | | | | | | PR: In my case, there was an element of luck. I was comfortable around a pulse oximeter. I knew my way around an electrocardiogram. And I could help people the way I'd been trained. What I didn't know back then was how to treat the root cause of an issue.
Now, I'm not unique here. America has an aging problem... but it's not that we're getting older. It's that so many folks aren't addressing the things that speed up the aging process.
For me, I happened to come across some research that found that off-balance hormone levels could lead to cognitive issues. So I got tested. And sure enough, I'd entered andropause.
Low testosterone levels were the culprit behind my brain fog. But once I got that fixed, I was back to my ol' self.
MM: So in your case, it was just basically a lack of information that was causing you to feel older, faster?
PR: Exactly. And that's the case for most folks. Look, this isn't just about hormones. It's about staying healthy and feeling younger even as we get older. The average person doesn't know how to slow the aging process. Most doctors don't either, for that matter. That's what's frustrating to so many folks about the healthcare system.
They go to the doctor. They wait too long. And after a couple of minutes of actually talking with the doc, they're given a pill for whatever they came in for and are sent on their way.
Now, that pill might offer some temporary relief... but nine times out of 10, it's not curing anything. At best, it's just treating the symptoms and allowing the cause to fester.
And that's most definitely the case when it comes to getting older. Try going to a conventional doctor and asking them to help slow the aging process. They'll look at you like you've got three heads.
MM: Right! Nobody's taught that in med school.
PR: And that right there is the problem.
Look, it took a near-personal tragedy for me to get my ducks in a row. So I'm not blaming anyone.
But once I figured out how to turn back the clock for myself, I immediately went back to school. I had to learn more to be able to share it with others.
That's how I wound up enrolling in a comprehensive training program at the American Academy of Anti-Aging Medicine.
So I continued to work in the ER. And even with my renewed focus, it was tough splitting my time between work and studying. But it was totally worth it.
I got to study under some of the most innovative doctors and researchers I'd ever worked with.
It was life-changing.
MM: So what did you discover while studying there?
PR: Among other things, I found that the whole concept built around the aging process is bunk.
Diet, exercise and even genes - to a certain extent - play a role. Most people already have a grasp on that.
But still, lots of folks are missing a crucial piece of the puzzle in order to look and feel younger.
And it's a piece that lives deep in our bodies... at the cellular level.
If we can get our cells to act and feel as if they're younger, it has the potential to rapidly turn back the clock.
Suddenly blood can flow better. The memory can get sharper. Metabolism can speed back up.
MM: In other words, if we can make our cells younger, it makes our whole body look, feel and act younger?
PR: Exactly.
MM: Is this even possible?
PR: Absolutely. You just need to know how to start fighting the aging process in every cell in the body.
The key is a powerful little molecule that plays a critical role in cellular survival.
When we're young, our bodies produce a ton of it.
But as we get older, this changes. Our production slows down a lot by the time we hit 30. By the time we're 60? Our levels might just be half of what they were in our 30s.
So it's no coincidence that this happens to be when a lot of folks start to look and feel older.
MM: So if we can increase the production of this mystery molecule, we can turn back the aging process?
PR: Big-time. The research is amazing. And I can't wait to share it with readers.
Note: Tomorrow Dr. Roberts is going to reveal what could be the easiest - and most powerful - anti-aging solution you've ever seen. One that's designed to fight aging in every cell of your body.
It's the culmination of his decades of research into the root causes of aging. And it could be the perfect combination of cutting-edge science and natural health solutions. You won't want to miss it.
Do you have questions for Dr. Roberts on the aging process? Send us an email here. | | | | | | | | | | | | |
|

No comments:
Post a Comment
Keep a civil tongue.